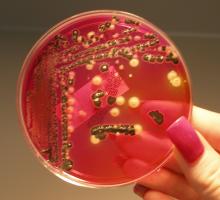
ACSH article image

The FDA's new comprehensive, two-year study tells us what we already knew: BPA, a chemical long-used to make certain types of plastics, poses no human risk. Yet, some members of JAMA, presumably one of the world's most respected medical journals, refuse to accept the science. And if that's not bad enough, the refusal wasn't written by a scientist, but by an English major.
The FDA's new comprehensive, two-year study tells us what we already knew: BPA, a chemical long-used to make certain types of plastics, poses no human risk. Yet, some members of JAMA, presumably one of the world's most respected medical journals, refuse to accept the science. And if that's not bad enough, the refusal wasn't written by a scientist, but by an English major.